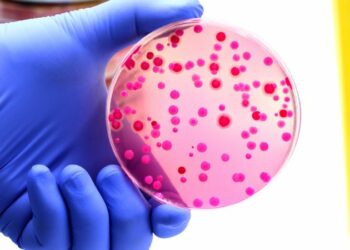
Antibiotics business model should be the flipside of pharma norm, says Shionogi Europe CEO – Euractiv Antibiotics business model should be the flipside of pharma norm, says Shionogi Europe CEO – Euractiv

Lundin selling pair of mines in Europe to Boliden AB in deal worth up to US$1.52B – NewmarketToday.ca
Source link : https://news.google.com/rss/articles/CBMi0AFBVV95cUxNcEVDSmxSUmRYek5LQ3pJTTNaTG5OZ0UzcDJzdzlQbDBuSDAxM0thdFAxRzBvcXQyV2I5TWlEVE1ReEdHa1JDdGFxcTRDa2hNbGxWSXVTaWU5ZzhnV3R0VVZsTHBRRTZQQU0zMEItbi1uSnhWQTAzRUFMVm1KSUFfcXBGWjMyb3RteU9kOExrQ2NQb2RuVVhSbjhMTzFtb0t4dTZtYzhEcXFUcFNCYjdzNWtqWTNXRFFzamFOTU5TOHZQZkZMVDJhTk9uNVUzampu?oc=5 Author : Publish date : 2024-12-09 13:30:00 Copyright for syndicated content belongs to the linked Source.